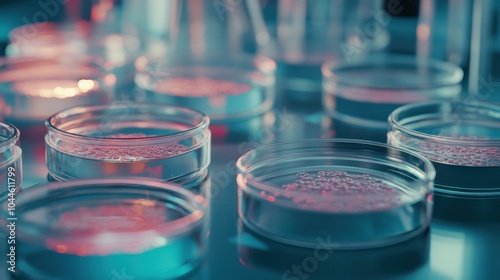

Download sample
File Details
Published: 2024-10-24 07:58:37.114763 Category: Science Type: Illustration Model release: NoShare
Close-up of stem cells in petri dishes, surrounded by precision tools for scientific breakthroughs in stem cell research. Laboratory setting
Contributor: 69
ID : 1044611799

